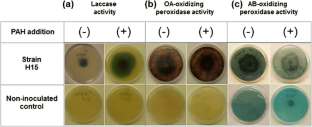

Abstract
Trichoderma asperellum H15, a previously isolated strain characterized by its high tolerance to low (LMW) and high molecular weight (HMW) PAHs, was tested for its ability to degrade 3–5 ring PAHs (phenanthrene, pyrene, and benzo[a]pyrene) in soil microcosms along with a biostimulation treatment with sugarcane bagasse. T. asperellum H15 rapidly adapted to PAH-contaminated soils, producing more CO2 than uncontaminated microcosms and achieving up to 78 % of phenanthrene degradation in soils contaminated with 1,000 mg Kg−1 after 14 days. In soils contaminated with 1,000 mg Kg−1 of a three-PAH mixture, strain H15 was shown to degrade 74 % phenanthrene, 63 % pyrene, and 81 % of benzo[a]pyrene. Fungal catechol 1,2 dioxygenase, laccase, and peroxidase enzyme activities were found to be involved in the degradation of PAHs by T. asperellum. The results demonstrated the potential of T. asperellum H15 to be used in a bioremediation process. This is the first report describing the involvement of T. asperellum in LMW and HMW-PAH degradation in soils. These findings, along with the ability to remove large amounts of PAHs in soil found in the present work provide enough evidence to consider T. asperellum as a promising and efficient PAH-degrading microorganism.

Similar content being viewed by others
References
Acevedo F, Pizzul L, Castillo MD, Cuevas R, Diez MC (2011) Degradation of polycyclic aromatic hydrocarbons by the Chilean white-rot fungus Anthracophyllum discolor. J Hazard Mater 185(1):212–219. doi:10.1016/j.jhazmat.2010.09.020
Ahmad M, Roberts JN, Hardiman EM, Singh R, Eltis LD, Bugg TD (2011) Identification of DypB from Rhodococcus jostii RHA1 as a lignin peroxidase. Biochemistry 50(23):5096–5107. doi:10.1021/bi101892z
Archibald FS (1992) A new assay for lignin-type peroxidases employing the dye azure B. Appl Environ Microbiol 58(9):3110–3116
Argumedo-Delira R, Alarcon A, Ferrera-Cerrato R, Almaraz JJ, Pena-Cabriales JJ (2012) Tolerance and growth of 11 Trichoderma strains to crude oil, naphthalene, phenanthrene and benzo[a]pyrene. J Environ Manage 95(Suppl):S291–S299. doi:10.1016/j.jenvman.2010.08.011
Atagana HI (2009) Biodegradation of PAHs by fungi in contaminated-soil containing cadmium and nickel ions. Afr J Biotechnol 8(21):5780–5789
Baldrian P (2006) Fungal laccases—occurrence and properties. FEMS Microbiol Rev 30(2):215–242. doi:10.1111/j.1574-4976.2005.00010.x
Bouchez M, Blanchet D, Vandecasteele JP (1995) Substrate availability in phenanthrene biodegradation: transfer mechanism and influence on metabolism. Appl Microbiol Biotechnol 43(5):952–960
Cazares-Garcia SV, Vazquez-Garciduenas MS, Vazquez-Marrufo G (2013) Structural and phylogenetic analysis of laccases from Trichoderma: a bioinformatic approach. PLoS One 8 (1).doi: 10.1371/journal.pone.0055295
Cerniglia CE, Sutherland GR (2010) Degradation of polycyclic aromatic hydrocarbons by fungi. In: Timmis KN (ed) Handbook of hydrocarbon and lipid microbiology. Springer, Berlin, pp 2079–2110. doi:10.1007/978-3-540-77587-4_151
Chernin L, Chet I (2002) Microbial enzymes in the biocontrol of plant pathogens and pests. In: Burns R, Dick R (eds) Enzymes in the environment: activity, ecology, and applications. CRC Press, Columbus, pp 171–226. doi:10.1201/9780203904039.ch7
Chutrakul C, Alcocer M, Bailey K, Peberdy JF (2008) The production and characterisation of trichotoxinpeptaibols, by Trichoderma asperellum. Chem Biodivers 5(9):1694–1706. doi:10.1002/cbdv.200890158
Conesa A, van den Hondel CA, Punt PJ (2000) Studies on the production of fungal peroxidases in Aspergillus niger. Appl Environ Microbiol 66(7):3016–3023
Cortes-Espinosa DV, Fernandez-Perrino FJ, Arana-Cuenca A, Esparza-Garcia F, Loera O, Rodriguez-Vazquez R (2006) Selection and identification of fungi isolated from sugarcane bagasse and their application for phenanthrene removal from soil. J Environ Sci Health A Tox Hazard Subst Environ Eng 41(3):475–486. doi:10.1080/10934520500428351
Cortes-Espinosa DV, Absalon AE, Sanchez N, Loera O, Rodriguez-Vazquez R, Fernandez FJ (2011) Heterologous expression of manganese peroxidase in Aspergillus niger and its effect on phenanthrene removal from soil. J Mol Microbiol Biotechnol 21(3-4):120–129. doi:10.1159/000331563
Cristica M, Manoliu A, Barbaneagra T, Ciornea E (2010) Compared analysis of catalase and peroxidase activity in cellulolytic fungus Trichoderma reesei grown on medium with different concentrations ofgrinded wheat and barley straws. An StiintUniv Al I Cuza Iasi, Sect II a Biol 12(3):89–93
de los Santos-Villalobos S, Guzmán-Ortiz DA, Gómez-Lim MA, Délano-Frier JP, de-Folter S, Sánchez-García P, Peña-Cabriales JJ (2013) Potential use of Trichoderma asperellum (Samuels, Liechfeldt et Nirenberg) T8a as a biological control agent against anthracnose in mango (Mangifera indica L.). Biol Control 64 (1):37-44. doi:http://dx.doi.org/10.1016/j.biocontrol.2012.10.006
Ding G, Chen AJ, Lan J, Zhang H, Chen X, Liu X, Zou Z (2012) Sesquiterpenes and cyclopeptides from the endophytic fungus Trichoderma asperellum SAMUELS LIECKF. & NIRENBERG. Chem Biodivers 9(6):1205–1212. doi:10.1002/cbdv.201100185
Druzhinina IS, Seidl-Seiboth V, Herrera-Estrella A, Horwitz BA, Kenerley CM, Monte E, Mukherjee PK, Zeilinger S, Grigoriev IV, Kubicek CP (2011) Trichoderma: the genomics of opportunistic success. Nat Rev Microbiol 9(10):749–759
Fawal N (2014) The PeroxiBase.TrichodermaasperellumPeroxidases. https://peroxibase.toulouse.inra.fr/tools/search.php?searchString[]=Trichoderma+asperellum&searchType[]=Organism&od=1.
Fawal N, Li Q, Savelli B, Brette M, Passaia G, Fabre M, Mathe C, Dunand C (2013) PeroxiBase: a database for large-scale evolutionary analysis of peroxidases. Nucleic Acids Res 41(Database issue):D441–D444. doi:10.1093/nar/gks1083
Hadibarata T, Kristanti RA (2012) Identification of metabolites from benzo[a]pyrene oxidation by ligninolytic enzymes of Polyporus sp. S133. J Environ Manage 111:115–119. doi:10.1016/j.jenvman.2012.06.044
Hadibarata T, Tachibana S (2010) Characterization of phenanthrene degradation by strain Polyporus sp. S133. J Environ Sci (China) 22(1):142–149
Hadibarata T, Tachibana S, Itoh K (2007) Biodegradation of phenanthrene by fungi screened from nature. Pak J Biol Sci 10(15):2535–2543
Hadibarata T, Yusoff AR, Aris A, Kristanti RA (2012) Identification of naphthalene metabolism by white rot fungus Armillaria sp. F022. J Environ Sci (China) 24(4):728–732
Haritash AK, Kaushik CP (2009) Biodegradation aspects of polycyclic aromatic hydrocarbons (PAHs): a review. J Hazard Mater 169(1-3):1–15. doi:10.1016/j.jhazmat.2009.03.137
Hidayat A, Tachibana S, Itoh K (2012) Determination of chrysene degradation under saline conditions by Fusarium sp. F092, a fungus screened from nature. Fungal biol 116(6):706–714. doi:10.1016/j.funbio.2012.04.004
Jaklitsch WM (2009) European species of Hypocrea Part I. The green-spored species. Stud Mycol 63:1–91. doi:10.3114/sim.2009.63.01
Juhasz AL, Naidu R (2000) Bioremediation of high molecular weight polycyclic aromatic hydrocarbons: a review of the microbial degradation of benzo[a]pyrene. Int Biodet Biodegr 45:57–88
Kuwahara M, Glenn JK, Morgan MA, Gold MH (1984) Separation and characterization of two extracelluar H2O2-dependent oxidases from ligninolytic cultures of Phanerochaete chrysosporium. FEBS Lett 169 (2):247-250. doi.10.1016/0014-5793(84)80327-0
Liers C, Arnstadt T, Ullrich R, Hofrichter M (2011) Patterns of lignin degradation and oxidative enzyme secretion by different wood- and litter-colonizing basidiomycetes and ascomycetes grown on beech-wood. FEMS Microbiol Ecol 78(1):91–102. doi:10.1111/j.1574-6941.2011.01144.x
Marx IJ, van Wyk N, Smit S, Jacobson D, Viljoen-Bloom M, Volschenk H (2013) Comparative secretome analysis of Trichoderma asperellum S4F8 and Trichoderma reesei Rut C30 during solid-state fermentation on sugarcane bagasse. Biotechnol Biofuels 6(1):172. doi:10.1186/1754-6834-6-172
Matsubara M, Lynch JM, De Leij FAAM (2006) A simple screening procedure for selecting fungi with potential for use in the bioremediation of contaminated land. Enzyme Microb Tech 39(7):1365–1372. doi:10.1016/j.enzmictec.2005.04.025
Nagai M, Sato T, Watanabe H, Saito K, Kawata M, Enei H (2002) Purification and characterization of an extracellular laccase from the edible mushroom Lentinula edodes, and decolorization of chemically different dyes. Appl Microbiol Biotechnol 60(3):327–335. doi:10.1007/s00253-002-1109-2
Ravelet C, Krivobok S, Sage L, Steiman R (2000) Biodegradation of pyrene by sediment fungi. Chemosphere 40(5):557–563
Reyes-Cesar A, Absalon AE, Fernandez FJ, Gonzalez JM, Cortes-Espinosa DV (2014) Biodegradation of a mixture of PAHs by non-ligninolytic fungal strains isolated from crude oil-contaminated soil. World J Microbiol Biotechnol 30(3):999–1009. doi:10.1007/s11274-013-1518-7
Saparrat MC, Margarita-Bucsinszky AM, Alfio-Tournier H, Cabello MN, Arambarri AM (2000) Extracellular ABTS-oxidizing activity of autochthonous fungal strains from Argentina in solid medium. Rev Iberoam Micol 17(2):64–68
Saraswathy A, Hallberg R (2002) Degradation of pyrene by indigenous fungi from a former gasworks site. FEMS Microbiol Lett 210(2):227–232
Seo JS, Keum YS, Li QX (2009) Bacterial degradation of aromatic compounds. Int J Environ Res Public Health 6(1):278–309. doi:10.3390/ijerph6010278
Sharon E, Chet I, Viterbo A, Bar-Eyal M, Nagan H, Samuels G, Spiegel Y (2007) Parasitism of Trichoderma on Meloidogyne javanica and role of the gelatinous matrix. Eur J Plant Pathol 118(3):247–258. doi:10.1007/s10658-007-9140-x
Slusarski C, Pietr SJ (2009) Combined application of dazomet and Trichoderma asperellum as an efficient alternative to methyl bromide in controlling the soil-borne disease complex of bell pepper. Crop Prot 28(8):668–674. doi:10.1016/j.cropro.2009.03.016
Smith PK, Krohn RI, Hermanson GT, Mallia AK, Gartner FH, Provenzano MD, Fujimoto EK, Goeke NM, Olson BJ, Klenk DC (1985) Measurement of protein using bicinchoninic acid. Anal Biochem 150 (1):76-85. doi:10.1016/0003-2697(85)90442-7
Su SM, Zeng XB, Bai LY, Li LF, Duan R (2011) Arsenic biotransformation by arsenic-resistant fungi Trichoderma asperellum SM-12F1, Penicillium janthinellum SM-12F4, and Fusarium oxysporum CZ-8F1. Sci Total Environ 409(23):5057–5062. doi:10.1016/j.scitotenv.2011.08.039
Tabak HH, Lazorchak JM, Lei L, Khodadoust AP, Antia JE, Bagchi R, Suidan MT (2003) Studies on bioremediation of polycyclic aromatic hydrocarbon-contaminated sediments: bioavailability, biodegradability, and toxicity issues. Environ Toxicol Chem 22(3):473–482
Thion C, Cebron A, Beguiristain T, Leyval C (2013) Inoculation of PAH-degrading strains of Fusarium solani and Arthrobacter oxydans in rhizospheric sand and soil microcosms: microbial interactions and PAH dissipation. Biodegradation 24(4):569–581. doi:10.1007/s10532-013-9628-3
Tien M, Kirk TK (1988) Lignin peroxidase of Phanerochaete chrysosporium. In: Willis A. Wood STK (ed) Methods in Enzymology, vol Volume 161. Academic Press, pp 238-249.doi:http://dx.doi.org/10.1016/0076-6879(88)61025-1
Todd SJ, Cain RB, Schmidt S (2002) Biotransformation of naphthalene and diaryl ethers by green microalgae. Biodegradation 13(4):229–238
Tondje PR, Roberts DP, Bon MC, Widmer T, Samuels GJ, Ismaiel A, Begoude AD, Tchana T, Nyemb-Tshomb E, Ndoumbe-Nkeng M, Bateman R, Fontem D, Hebbar KP (2007) Isolation and identification of mycoparasitic isolates of Trichoderma asperellum with potential for suppression of black pod disease of cacao in Cameroon. Biol Control 43(2):202–212. doi:10.1016/j.biocontro1.2007.08.004
US-EPA (2008) Polycyclic aromatic hydrocarbons (PAHs). Office of Solid Waste, United States Environmental Protection Agency.http://www.epa.gov/wastes/hazard/wastemin/minimize/factshts/pahs.pdf. Accessed March 2012
Verdin A, Sahraoui L, Durand R (2004) Degradation of benzo[a]pyrene by mitosporic fungi and extracellular oxidative enzymes. Int Biodeter Biodegr 53(2):65–70. doi:10.1016/j.ibiod.2003.12.001
Wojcieszynska D, Guzik U, Gren I, Perkosz M, Hupert-Kocurek K (2011) Induction of aromatic ring: cleavage dioxygenases in Stenotrophomonas maltophilia strain KB2 in cometabolic systems. World J Microbiol Biotechnol 27(4):805–811. doi:10.1007/s11274-010-0520-6
Wu Y, Luo Y, Zou D, Ni J, Liu W, Teng Y, Li Z (2008) Bioremediation of polycyclic aromatic hydrocarbons contaminated soil with Monilinia sp.: degradation and microbial community analysis. Biodegradation 19(2):247–257. doi:10.1007/s10532-007-9131-9
Yuan SY, Chang SW, Chang BV (2003) Biodegradation of polycyclic aromatic hydrocarbons in sludge. Bull Environ Contam Toxicol 71(3):625–632
Zafra G, Absalón ÁE, Cuevas MC, Cortés-Espinosa DV (2014) Isolation and selection of a highly tolerant microbial consortium with potential for PAH biodegradation from heavy crude oil-contaminated soils. Water Air Soil Poll 225(2):1826. doi:10.1007/s11270-013-1826-4
Acknowledgments
This work was supported by Consejo Nacional de Ciencia y Tecnología (CONACYT) project CB2008-105643, Instituto Politécnico Nacional project SIP20144071 and CONACYT grant 269828.
Author information
Authors and Affiliations
Corresponding author
Additional information
Responsible editor: Robert Duran
Rights and permissions
About this article
Cite this article
Zafra, G., Moreno-Montaño, A., Absalón, Á.E. et al. Degradation of polycyclic aromatic hydrocarbons in soil by a tolerant strain of Trichoderma asperellum . Environ Sci Pollut Res 22, 1034–1042 (2015). https://doi.org/10.1007/s11356-014-3357-y
Received:
Accepted:
Published:
Issue Date:
DOI: https://doi.org/10.1007/s11356-014-3357-y




